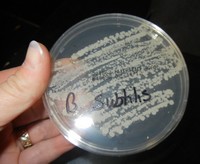

AP Biology Labs
AP Biology Labs
The AP college board lists 13 labs for its recommended curriculum, summarized in the publication, AP Biology Investigative Labs. However, teachers are not limited to only using their versions of the lab. AP biology teachers submit a curriculum for review and approval and must include laboratory exercises that align with their core ideas. Some of the recommended labs may be too expensive or too time consuming for your class. Listed below are some alternatives that may be acceptable as part of your overall biology curriculum.
| Big Idea | Recommended Lab (AP Biology) |
Possible Alternatives | Notes |
|---|---|---|---|
EvolutionEvolution drives the diversity and unity of life. Supported by evidence from many scientific disciplines, Darwin’s theory of evolution states that heritable variations occur in individuals in a population; because of competition for resources, individuals with more favorable phenotypes are more likely to survive and reproduce, thus passing traits to offspring.
|
Investigaton 1: "Can extreme selection change expression of a quantitative trait in a population in one generation?" Grow Fast Plants for 1-2 generations, quantify traits and select parents for next generation
|
Evolution Lab - simulation showing how organisms evolve over time in response to environmental conditions Natural Selection at PHET - another simulation showing wolf and rabbit populations Sex and the Single Guppy - simulation that examines sexual selection (flash documents no longer work with most browsers) Case Study: "I'm Looking Over a White-Striped Clover" - an investiation of clover adaptations Evolution of the Origami Bird - this uses a paper model that flies, coin flips represent variations in wing position and length |
Fast Plants are easy to grow, and Fastplants.org has many hints and suggestions for cheaply growing the plants Simulations and Case Studies can be performed outside of class
|
Investigaton 2: "How can mathematical models be used to investigate the relationship between allele frequencies in populations of organisms and evolutionary change?" |
Count individuals and use the HW equation to determine allele frequences Hardy Weinberg Simulation - uses beads to represent alleles, track changes in generations using students as "parents" Hardy Weinberg and Rock Pocket Mouse - use real data to analzye how allele frequencies change in a population Teddy Graham Lab - sad and happy teddy graham can be used to gather data and analye allele frequencies |
AP Lab uses a spreadsheet to model allele frequencies, the data input instructions are very involved, but can be a way to introduce students to spreadsheets Hardy Weinberg equation is included on the AP Test, students do not need to memorize it, but they should know how to use it |
|
Investigation 3: How can bioinformatics be used as a tool to determine evolutionary relationships and to better understand genetic diseases? |
Bacterial ID Lab at HHMI - this includes a BLAST section and a simulation of isolated and identifying bacteria using PCR amplification Name That Gene - using blast, identify genes using DNA sequences Constructing a Cladogram - drawings are used to infer relationships and create a cladogram Cladogram Analysis -image of a cladogram of arthropods where students determine derived characteristics and create their own cladogram Examining the Fossil Record - fossils are arranged on a poster to show how each are related and how speciation can occur Are Bats Birds? - short version using protein sequences from Uniprot to creaty phylogenies |
Using BLAST can be time consuming, though much of the lab can be performed outside of class Students should definitely know how to analyze a cladogram before taking the AP Biology Test
|
|
Cellular ProcessesBiological systems utilize free energy and molecular building blocks to grow, reproduce, and maintain dynamic homeostasis. Organisms have evolved various strategies to capture, use, and store free energy and other vital resources. |
Investigation 4: Diffusion and Osmosis What causes plants to wilt if they are not watered?
|
Diffusion and Osmosis - a modified version of the lab, measure mass change in sucrose dialysis tubes and calculate water potential Diffusion Lab - very simple observation lab that shows the movement of iodine through a bag, using cornstarch as an indicator Salt and Elodea Cells - observe how cells change when soaked in a hypertonic solution
|
This lab requires some set-up with dialysis tubes and sucrose solutions Diffusion lab is very basic and may only be appropriate for pre-AP classes or as a demonstration |
Investigation 5: Photosynthesis What factors affect the rate of photosynthesis in living leaves? |
Photosynthesis Simulation - change light intensity and wavelenght and compare the amount of ATP produced Waterweed Simulator - Adjust light and CO2 levels, measure photosynthesis by counting bubbles Rate of Photosynthesis – using baking soda, elodea and light, measure the bubbles to observe how fast a plant photosynthesizes and releases oxygen Investigation: Photosynthesis - this lab uses leaf disks that float to indicate photosynthesis. Students investigate factors that affect photosynthesis. - modified AP Lab |
|
|
Investigation 6: Cellular Respiration What factors affect the rate of cellular respiration in multicellular organisms? |
Virtual Lab: Cellular Respiration - a step-through activity that mirrors the procedure of the investigation Cellular Respiration - modified AP lab, uses respirometers to measure oxygen consumption |
This lab requires equipment that may be hard to obtain or create. You can order respirometer and lab kits from Carolina | |
Genetics and Information TransferGenetic information provides for continuity of life, and, in most cases, this information is passed from parent to offspring via DNA. In eukaryotic organisms, heritable information is packed into chromosomes that are passed to daughter cells by mitosis, a controlled mechanism that ensures that each daughter cell receives an identical and complete complement of chromosomes. |
Investigation 7: How do eukaryotic cells divide to produce genetically identical cells or to produce gametes with half the normal DNA? Part 1) Modeling Mitosis |
Mitosis Internet Lesson- Mitosis in an Onion Root - view slides and count the number of cells visible in each stage The Case of the Dividing Cell - case study where students learn stages of mitosis and meiosis, prokaryote versus eukaryote Modeling Chromosomal Inheritance - using beads and pipe cleaners to show how genes are passed from parents to offspring Linkage Group Simulation - pipecleaners are used to model crossing over Investigation: Mitosis - look at slides and real data from a cancer study to explore the role of P53 in the cell cycle |
Many of the activities listed in the investigation can be performed as classroom discussions, lectures, and animations.
|
Investigation 8: How can we use genetic engineering techniques to manipulate heritable information |
Transgenic Fly Virtual Lab - HHMI uses a virtual lab to insert DNA into flies which are used to study circadian rhythms Bacteria Lab - introduces bacteria, agar, culturing and staining Torn at the Genes - case study on GM foods Recombinant DNA Simulation - using paper to model how restriction enzymes can be used to modify DNA |
Bacterial Transformation kits can be purchased from Carolina
|
|
Investigation 9: How can we use genetic information to to identify and profile individual? |
DMD Electrophoresis Lab - uses electrophoresis to analyze DNA samples from a family to determine who are carries of duchenne muscular dystrophy DNA Extraction - extract DNA from a strawberry |
Electrophoresis equipment is expensive, local colleges and universities may be willing to loan you equipment DNA extractions are simple and require very little equipment |
|
InteractionsLiving systems from cells to ecosystems require free energy and matter to maintain order, grow, and reproduce, with organisms using various strategies to capture, use, and store free energy and other resources. |
Investigation 10: What factors govern energy capture, allocation, storage, and transfer between producers and consumers in a terrestrial ecosystem? |
Build an Ecosystem - grown plants and snails in jars and record changes in levels of CO2 by using btb as an indicator Virtual Lab: Population Biology - observe the competitive exclusion principle in populations of paramecium Where do Plants Get Their Food? - investigate ways to measure biomass and plant growth using bean seedlings Bottle Biology - using 2 liter bottles, investigate factors that affect ecosystems Case Study - The Fish Kill Mystery - investigate what may have caused a fish kill, explore excess nutrients and life cycles of microorganisms Case Study - The Gulf's Dead Zone - presentation case that presents information and asks students to evaluate, analyze and make recommendations |
The basics of this experiment include growing plants and animals together and then measuring the biomass of the plants. This experiment is a long term investigation and requires space and maintenance.
|
Investigation 11: What factors, including environmental variables affect the rate of transpiration in plants? |
AP Lab - Transpiration - using seedlings and plastic bags, measure the rate at which water is lost in different conditions | The whole plant method in the Lab Guide may be a simpler way to complete this requirement, also using bags, strings and a seedling | |
Investigation 12: What environmental factors trigger a fruit fly response? |
Isopod Behavior Lab - uses ispods (rollypollys) to investigate animal behavior Daphnia Heart Rate Lab - expose crustaceans to chemicals and measure responses |
This lab is simple and fun for the students, very little background information is needed to complete it and may be a good beginning of the year experiment | |
Investigation 13: How do abiotic or biotic factors influence the rates of enzymatic reactions? |
Enzyme Lab - Using liver and hydrogen peroxide, observe enzyme actions in a variety of conditions (temperature, acidity) Enzyme Investigation on Substrate Concentrations - use yeast to create a catalase solution. Filter paper soaked in this solution will sink and then float in hydrogen peroxide as a measure of the rate of oxygen being produced |
This lab may fit better during the cell unit when discussiong organic molcules | |